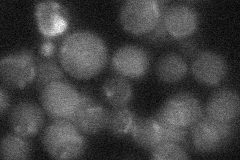
YDR524C
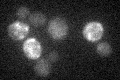
YDR524C

View description
ADP-ribosylation factor (ARF) GTPase activating protein (GAP) effector, involved in the secretory and endocytic pathways; contains C2C2H2 cysteine/histidine motif
Localization:
Intensity:
Fold change:
Significance:
-
C’ GFP library in SD

below threshold14.52 -
N' NOP1pr-GFP in SD

punctate33.5935 -
N' TEF2pr-mCherry in SD

cytosol11.6521 -
N' NATIVEpr-GFP in SD
below threshold19.7891 -
N' TEF2pr-VC and Cyto-VN in SD

below threshold24.5989 -
C’ GFP library in SD+DTT

cytosol18.721.28No -
C’ GFP library in SD+H2O2

cytosol17.461.2No -
C’ GFP library in Starvation Media
cytosol15.121.04No -
C’ GFP library on the background of Pup2-DaMP

below threshold -
C’ GFP library on the background of CCT mutant

below threshold16.45841.13252No
